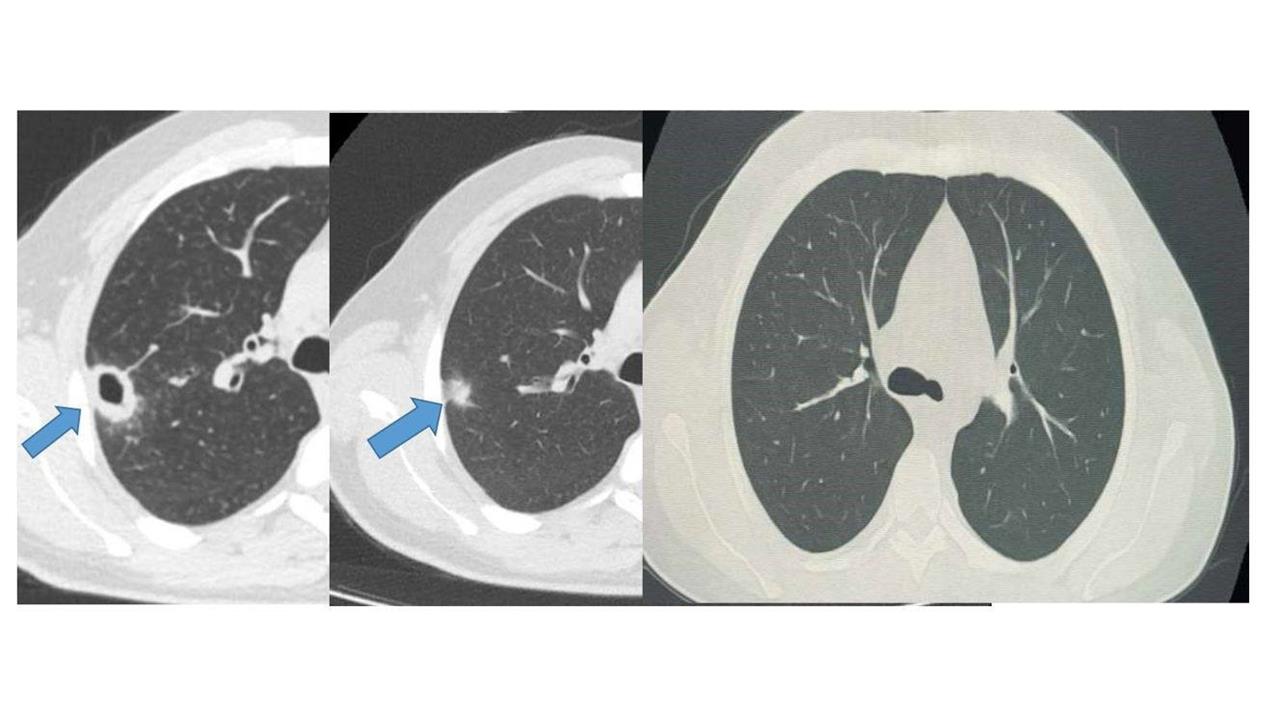
Bayburt'ta Erken Tanı ile Sağlığına Kavuşan Hasta

Erken Tanı ve Tedavi Süreci
Hastanın muayenesini gerçekleştiren Göğüs Hastalıkları Uzmanı Uzm. Dr. Hilal Sayma, ileri tetkik amacıyla bronkoskopi işlemi uyguladı. Bronkoskopi sonucunda tespit edilen lezyonun kanser veya tüberküloz gibi ciddi hastalıklarla ilişkili olmadığı belirlendi. Bu aşamadan sonra hasta için uygun tedavi süreci başlatıldı.
Sağlığına Kavuştu
İki haftalık tedavi sürecinin ardından yapılan kontrollerde lezyonun neredeyse tamamen gerilediği görüldü. Sonuç olarak sağlığına kavuşan hasta taburcu edildi ve durumunun iyi olduğu belirtildi. Bu örnek, erken tanının ne denli önemli olduğunu bir kez daha gözler önüne serdi.